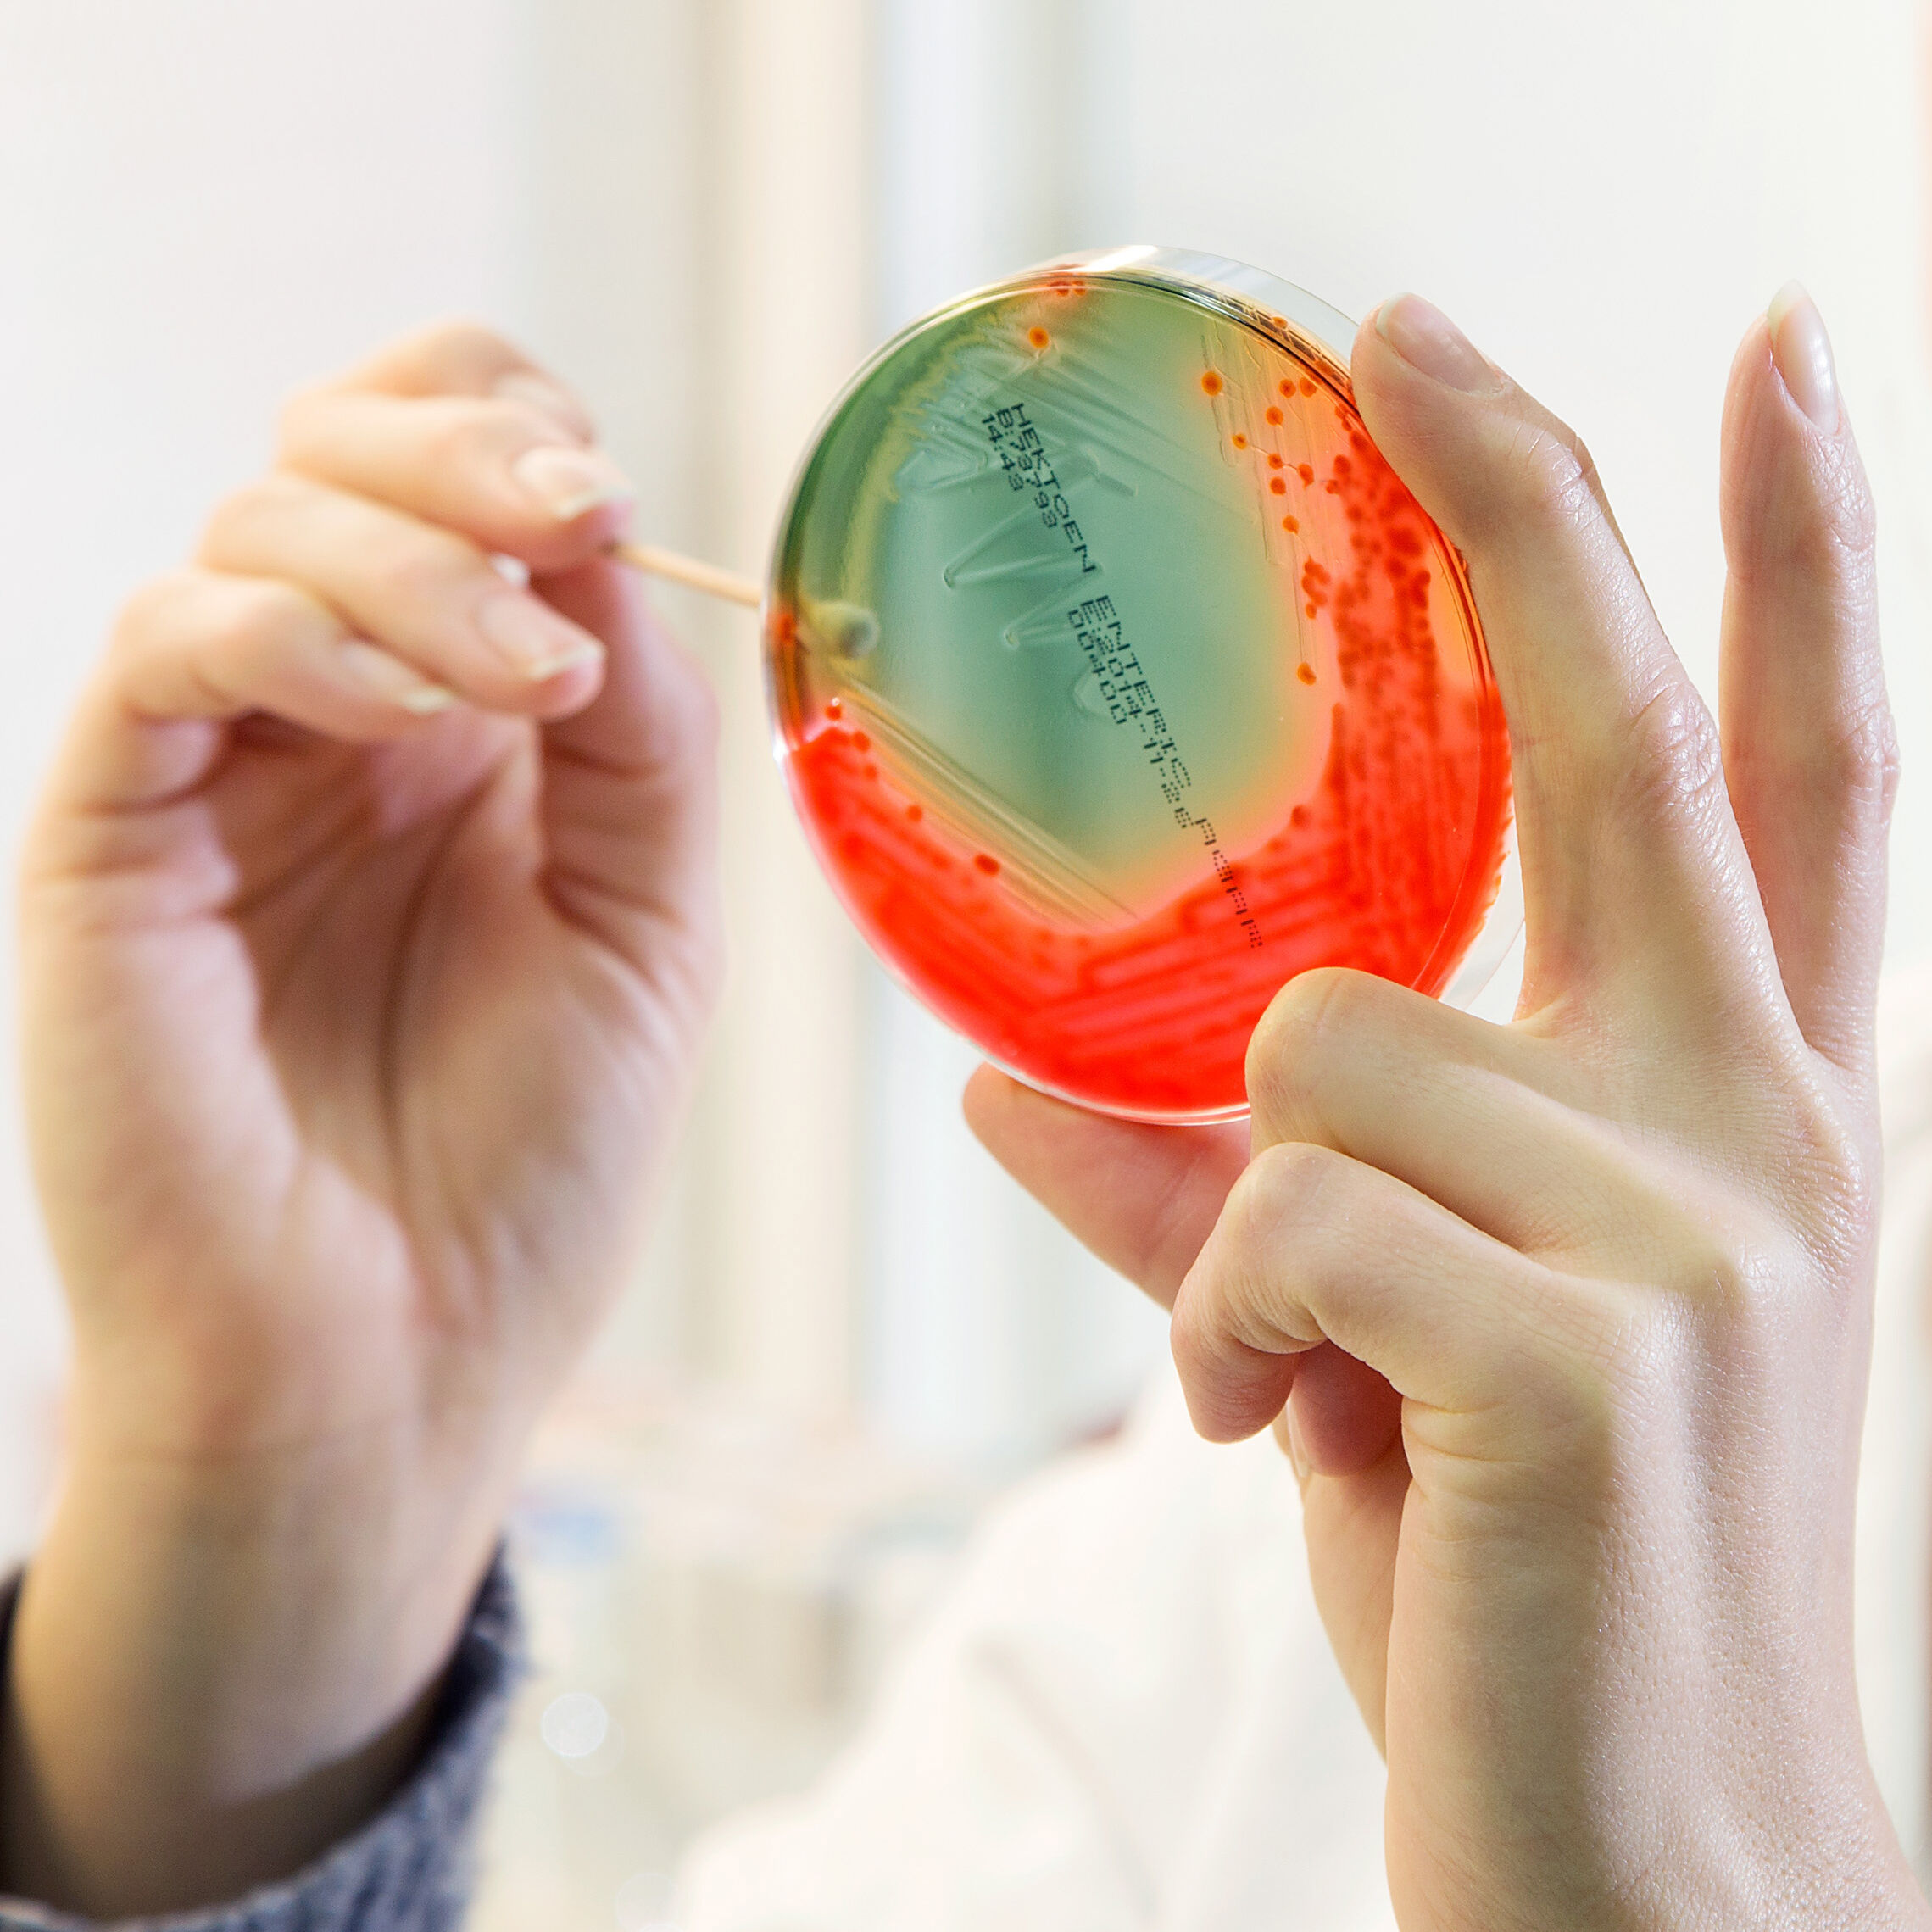

Aplicación
La solución de SteryShield RTU está lista para usarse, no requiere dilución. Se puede aplicar por aspersión, nebulización o sumergimiento.
Aplicaciones
Desinfección de superficies duras para la industria agroalimentaria, pet food y procesado de alimentos en general.
- Superficies, transportadores.
- Áreas de empaque, equipos, cajas y charolas.
- Almacenes y cuartos fríos.
- Vehículos de transporte y montacargas.
- Herramientas y utensilios.
- Bandas, transportadores.
- Sanitización de superficies en general.